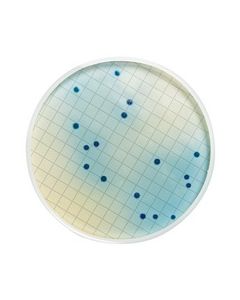
MB000000F.jpg

The store will not work correctly when cookies are disabled.
- Você quis dizer
-
conjunto filtracao millipore
-
conjunto filtrado millipore
- Termos de pesquisa relacionados
-
CONJUNTO DE REAGENTES E TUBOS PARA ANÁLISES DE CROMO TOTAL E HEXAVALENTE,
-
conjunto de filtração com pinça
-
conjunto de filtracao com ponta
-
conjunto de filtraca
-
conjunto de filtracao com preta

DISPOSITIVO ULTRAFILTRACAO AMICON ULTRA-15 3KDA MEMBRANA DE CELULOSE REGENERADA (CX C/8) MILLIPORE
Modelo: UFC900308
R$ 795,83

MONITOR 2 PECAS EM POLIESTIRENO SEM MEMBRANAS INCLUINDO PLUGS VERMELHOS E AZUIS (CX) MILLIPORE
Modelo: M00003700
R$ 1.097,93

MONITOR 3 PECAS EM POLIESTIRENO SEM MEMBRANAS INCLUINDO PLUGS VERMELHOS E AZUIS (CX) MILLIPORE
Modelo: M000037A0
R$ 1.147,38

MONITOR 37mm EM TENITE PARA ANALISE DE CONTAMINAÇÃO DE FLUIDOS 2 PECAS (CX) MILLIPORE
Modelo: M000037P0
R$ 1.555,31

AGITADOR ROTATIVO P/ SISTEMA ZHE E SOLUBILIZADO MILLIPORE (CAPAC. PARA 4 SUPORTES 115V/60Hz)
Modelo: YT310RAHW
R$ 44.906,09

MILLEX LG UNID. FILTRANTE HIDROFILICO PTFE FLUOROPORE DIAM. 25mm PORO 0,22um (50/CX) MILLIPORE
Modelo: SLLGC25NS
R$ 1.913,20

MEIO M FC DESIDRATADO FRASCO COM 113,5g PARA DETERMINACAO DE COLIFORMES FECAIS (EMB) MILLIPORE
Modelo: MB000000F
R$ 1.114,29

SUPORTE MESOPENER EM ACO INOX PARA SECAGEM E ABERTURA DO FILTRO MICROPRESURE (UND) MILLIPORE
Modelo: MS0PENR01
R$ 39.272,59

MANIFOLD 6 POSIÇÕES EM AÇO INOX TESTE ESTERILIDADE PARA 6 PROVAS SIMULTANEAS (UND) MILLIPORE
Modelo: XX2504758
R$ 39.362,51

CARTUCHO QUANTUM IX E FILTRO FINAL MILLIPAK 40 MILLIPORE - P/ MILLI-Q ( 1/CJ)
Modelo: QTUMMPKIX
R$ 2.835,16

PEPTONA REAG FATOR CRESCIMENTO HEPATOCITO RECOMBINANTE HUMANO TEMPERATURA TRANSPORTE ARMAZENAMENTO -20C 10UG (UND) MILLIPORE
Modelo: GF116
R$ 2.407,79

MEMBRANA PVDF IMMOBILON-FL 0,45um 20 X 20cm PARA TRANSFERENCIA DE PROTEINA (CX) MILLIPORE
Modelo: IPFL20200
R$ 1.508,85